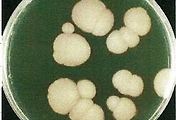

항생제(antibiotics)라고 불리는 약들은, 보통 항세균제(anti-bacterial) 로, 세균에는 효과가 있으나, 진균(곰팡이)에는 효과가 없습니다.
반대로, 진균에 듣는약들은 항-진균제(anti-fungal)라고 불리며, 세균에는 효과가 없습니다.
물론, 비가목스와 같은 일부 항세균제는 진균에 효과가 있다고는 하지만.. 일부의 이야기입니다. (참조 : [링크])
따라서, 각막염환자에서, 이 원인이 세균인지, 진균인지를 감별해 내는것이 초기 치료 약제를 선택하는데 중요할 것입니다.
사상진균에 의한 진균각막염의 경우, 그 임상 양상이 워낙 특징적이라서, 임상적인 진단만으로도, 곰팡이에 의한 감염임을 알수 있습니다. (참조 : [링크])
하지만, 효모에 의한 각막염의 경우, 세균에 의한 각막염과 양상이 비슷하기 때문에, 임상양상만으로는 구분이 힘든 경우가 많습니다. (참조 : [링크])
따라서, 세균성 각막염인지, 진균성 각막염인지를 감별하고, 초기 치료 방향을 결정하는데 있어서, 원인 균의 동정 검사는 매우 중요합니다.
이전 포스팅을 통해서... 세균각막염에서 시행하는 각막 찰과검사 및 도말검사에 대해서 알아보았습니다.
[안과 질환과 안과 치료/각막 외안부]
세균 각막염 (각막궤양)의 진단 : 각막 찰과검사, 생검, 도말검사, 배양검사
세균각막염(bacterial keratitis)에서 시행하는...
각막 찰과검사는... 원인균을 알기 위한 검사인, 도말 검사와 배양검사를 시행하기 위해 검체채취 (specimen sampling) 하는 과정이고,
도말검사는... 비교적 오래 걸리는 배양검사의 결과를 기다리면서, 원인 세균에 대해서 미리 정보를 얻고자 하는 검사입니다. 그람 양성인지, 음성인지의 여부 뿐 아니라, 때로는 이러한 도말검사만으로도, 원인균의 정체를 알수 있기도 합니다.
진균에서 시행하는... 각막 찰과검사와 도말검사 역시 동일한 원리가 적용됩니다.
각막 찰과검사를 통해, 검체를 채취하여, 도말검사와 배양검사를 시행하게 되고,,
도말검사는... 배양검사 이전 원인 균주에 대한 힌트(단서)를 얻기 위함입니다.
<진균 각막염에서 시행하는 각막 찰과검사(corneal scraping)>
세균의 경우, 검채 채취를 할때... 소독된 면봉으로 Swab 하는 것만으로도 세균 채취가 충분한 경우가 있습니다.


하지만, 진균, 곰팡이는... 세균과는 달리 조직의 심층부에 진균이 있을 가능성이 있습니다.
소독된 면봉보다는.. 소독된 백금자나 수술칼로 각막 궤양부를 적극적으로 찰과해야 합니다.
특히, 염증의 기저부와 가장자리에서 여러개의 표본을 얻는것이 중요합니다.


특히 진균 각막염이 진행하였을시에는.. 적극적인 각막 찰과검사에도 불구하고,,,
진균이 진행된경우.. 상층부 기질이나, 궤양 경계부에서는 잘 발견되지 않는 경우가 있는데...
독성이 높은 균사들은 각막 실질에 평행하게 존재하는 것보다, 직각으로 존재하는 경우가 더 많기 때문입니다.

특히 스테로이드를 점안한 환자에서 실질에 직각으로 존재하는 균사가 많이 관찰되어 이를 뒷받침해줍니다.
전방천자의 경우... 내피반이나, 전방축농이 있는 경우 전방천자를 시행할수 있습니다.

세균성 각막염에서 전방축농은 무균상태이기 때문에, 전방천자를 하지 않는것에 반해서...
진균의 경우, 각막의 심부 깊숙히 침범하는 경향이 있어, 전방축농에서도 균이 발견되는 경우가 있습니다.
하지만, 전방천자 도중, 각막 표면에서 안내로 진균이 전이가능하고, 전방천자 자체에 의한 염증 증가 가능성이 있어 초기에는 권유하지 않습니다.
<진균 각막염에서 시행하는 도말검사와 염색검사>
1. 그람 염색(gram stain)
사상진균의 원형질에 의해서 흡수되어, 진균은 Gram 양성 처럼 푸르게 나타납니다.


2. 김자 염색(Giemsa stain)
김자 염색은... 진균의 특징적인 형태 관찰을 위해서 진균 염색에 흔히 사용됩니다.

3. KOH smear (Potassium hydroxide)
KOH test역시 사용될수 있으나, 10~20% 정도로 신뢰도가 떨어진다는 단점이 있습니다.

4. GMS 염색 (Gomori Methenamine Silver, Grocott's methenamine silver stain)
고모리메테나민은염색 (메테나민 실버 염색)은... 진균을 검게 염색해 줍니다.
그람염색이나, 김자 염색에 비해서 정확도가 높으며.. 진균에 가장 특이적인 염색법입니다.


5. PAS 염색(Periodic Acid Schiff)
PAS염색에서 균사는 선홍색으로 염색됩니다.

6. Acridine orange 염색 (아크리딘 오렌지)
아크리딘 오렌지 염색은 형광 현미경을 이용하여 관찰하는 것으로,
검은 바탕에서 밝은 오렌지색으로 나타납니다.

7. Calcofluor white staining
KOH smear 와 Calcofluor white stain 을 같이 사용하면 Gram stain 보다 우수하다고 알려져있습니다.
따라서 진균이 의심되면 그람 염색 이외에, 이 두가지를 추가하면 도움이 된다고 합니다.

지금까지....
진균 각막염의 각막 찰과 검사와, 도말검사, 염색 검사 : 원인 균사의 동정에 대해서 알아보았습니다.
진균 각막염의 분류와 위험인자 : [링크]
사상진균에 의한 진균각막염의 임상양상 : [링크]
효모에 의한 진균각막염의 임상양상 : [링크]
진균 각막염의 각막 찰과 검사와, 도말검사 : [링크]
진균 각막염의 배양 검사 : [링크]
진균 각막염의 내과적 치료 : [링크]
진균 각막염의 외과적 치료 : [링크]
'안과 질환과 안과 치료 > 각막 외안부' 카테고리의 다른 글
| 진균 각막염의 내과적 치료 : 항진균제 사용 : 암포테리신, 나타마이신(나타신), 보리코나졸 (0) | 2017.12.13 |
|---|---|
| 진균 각막염의 진단을 위한 배양 검사(culture)와 배지(agar)의 종류, 대표적인 진균의 배양 검사 결과 (0) | 2017.12.13 |
| 진균 각막염, 곰팡이 각막염(fungal keratitis, fungal corneal ulcer)의 분류와 위험인자 (0) | 2017.12.13 |
| 아데노바이러스(adenovirus)에 의한 유행성각결막염(EKC), 인후 결막염 (PCF), 단순결막염 (2) | 2017.12.13 |

댓글